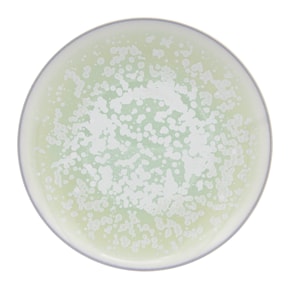
Jaune de Chrome, Song Amande, Dinner plate

Bread & Butter Plates
About
Classic, elegant formal settings, as well as modern luxury table arrangements, involve many fundamental elements. And the bread and butter plate is yet another vital component, especially when it comes to the proper serving of baked goods or simply for dining convenience—for instance, when you need a slice of flavorful bread for the strategic pairing of a specific dish. It might seem like such a miniature piece, yet it can exist in different forms—either minimal and discreet or, conversely, richly decorated, creating an eccentric visual magnet.
Meet the Bread and Butter Plate in Table Setting
In a standard dinnerware set, B&B plates are always the smallest in size. Different manufacturers offer varying diameters, but traditional sizes generally range from 15 to 18 cm (about 6 to 7 inches), depending on the complexity of the shape. To avoid confusing them with tea or coffee saucers, note that these plates are completely flat. This design is not accidental—according to etiquette, the set always includes a special knife that can be used to cut bun on the plate and spread butter.
You will always easily find the items on the table, as etiquette rules have designated a specific spot for them: on the guest's left side, symmetrical to the glasses on the right, and aligned with the top edge of the charger or slightly above the dinner forks. Always place it there, so that you can take the roll with your left hand and hold the utensil with your right.
Variations for Using
Not only in festive table settings but also in everyday use, bread and butter plates find practical application. They are primarily designed for small baked goods: rolls, slices of bread, croutons, and individual portions of spread. But you can also use them to present your signature pastries to guests, gourmet appetizers, or for breakfast—sandwiches, a bit of pâté, or even a dollop of jam. There are simply no special restrictions on their use, so in complex tablescapes, you can use them as coasters for sauce boats and caviar servers, or even to serve a baked compliment from the chef.
How to Choose a Bread and Butter Plate
Our MDMAISON team recommends choosing pieces based on two main concepts.
First — either order pieces to match your main set, or select a style and material that coordinates with it. And of course, take the color palette into account; it should either be similar or harmoniously complement the lead color.
The second — and easiest way — is to order elegant white bread plates. Many European manufacturers of luxury porcelain produce entire lines of items where you can choose collections to support your presentation ideas, such as Bernardaud, Robert Haviland & C. Parlon, Rosenthal, J.L Coquet, Hering Berlin, and so on.
If you lack the time for extensive searching or are uncertain about finding the right objects, contact us for assistance. Our MDMAISON platform gives you access to some of the most exclusive and perfectly crafted collections of Limoges, German, and Italian dinnerware. We provide selection consultations and curate complex decor and table setting projects, so we will help you make an informed choice to ensure every detail looks impressive and remains functional.
FAQ
What size should a bread and butter plate be?
In various manufacturer catalogs, you may find diameters ranging from 15 to 18 cm, but no larger.
Where should the B&B plate go on the table?
In table setting architecture, this plate is always placed to the left of the main place setting.
What can I actually serve on these mini plates?
Feel free to use them for various individual servings, small cold appetizers, and also as a base for certain complex table settings.
Have questions?
We're here to guide you through styles, brands, and prices, addressing all your questions along the way